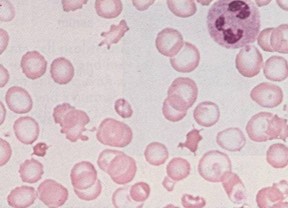

Medical Mystery of the Week
You have received your COVID19 immunizations but continue to practice telemedicine.
You are sent two pictures, one of the patient's foot and one of the patient's peripheral
blood smear (see Panels A and B below). You are given no other information.
What is your diagnosis, what test(s) would you order to confirm your suspicions, and
what treatment, if any, do you recommend?
DIAGNOSIS: An early stage of purpura fulminans in a patient with meningococcemia.
Invasive serotypes of meningococci are capable of penetrating the oropharyngeal
mucosal barrier and proliferating in and on vascular endothelial cells (VEC). Although
the nature of the virulence factor(s) accounting for mucosal penetration is unknown,
VEC adherence is made possible by the expression of type IV pili, a critical virulence
factor.
Meningococci not only grow in and on VEC, they also multiple within VEC intercellular
spaces causing vascular leakage. VEC damage also initiates a tissue factor-mediated
coagulopathy (thrombotic microangiopathy - see Panel B below) manifested clinically
as purpura and, in advanced stages, tissue necrosis (see Panel C below). Vascular
leakage can contribute to septic shock. Similar VEC invasion may occur in the central
nervous system causing meningitis.
The initial defense against meningococcal invasion is mediated by binding of
their lipopolysaccharides (endotoxins) to Type 4 toll-like receptors on circulating
macrophages. This prompts the release of the pro-inflammatory cytokines interleukin
(IL)-6, tumor necrosis factor-alpha, and interferon gamma. In turn, these factors
prompt hepatocytes to generate acute phase reactants. Polymorphonuclear leukocytes
are also mobilized.
Penicillin, given in high doses intravenously, remains the drug of choice for
patients with meningococcemia. Therapy should be instituted immediately in patients
suspected of having this disease, for any delay may result in death or loss of extremities.
Examination of peripheral blood leukocytes (the "buffy coat") of patients with
suspected microbial sepsis may provide a diagnosis and allow early initiation of directed
antimicrobial therapy (see Panels D and E, below).

Panel A. Purpura on the tips of toes 2 and 3 in a patient with early stage meningococcemia. Biopsies of these purpuric lesions typically show VEC retraction, capillary disruption, hemorrhages, adherent leukocytes, and formation of small thrombi.
Panel B
A Wright-Giemsa stain of the patient's peripheral blood shows changes typical
of a thrombotic microangiopathy (TMA) - schistocytosis (increased number of fragmented
eythrocytes) and thrombocytopenia (note the absence of platelets).
Although schistocytes are reported to comprise >1% of erythrocytes in patients
with TMA, they are not specific for this order. Levels of >1% have been seen in patients
with hematologic malignancies, renal failure, and hemoglobinopathies. Schistocytosis
of >1% may also be seen in neonatal infants.

Panel C. More advanced stage of meningococcemia with tissue necrosis

Panel D. Technique for isolating the leukocyte layer (buffy coat) in patients with suspected microbial sepsis. A variety of organisms may be seen when the leukocytes are layered and stained on a microscopic slide.

Panel E. Gram stain of a buffy coat containing phagocytized meningococci (arrows). Meningococci are Gram negative diplococci. They can be confused with other Gram negative diplococci including Neisseria gonorrhea and Moraxella catarrhalis.
Bonus Question: Why are petechiae red and purpura blue? Answer: this is the result of the skin's ability to block red colors (the opposite of Earth's atmosphere, which blocks blue colors). Hence, hemorrhages that are superficial (i.e., petechiae) are red whereas deeper hemorrhages (i.e., purpura) are blue.
Stout Drive Road Closure